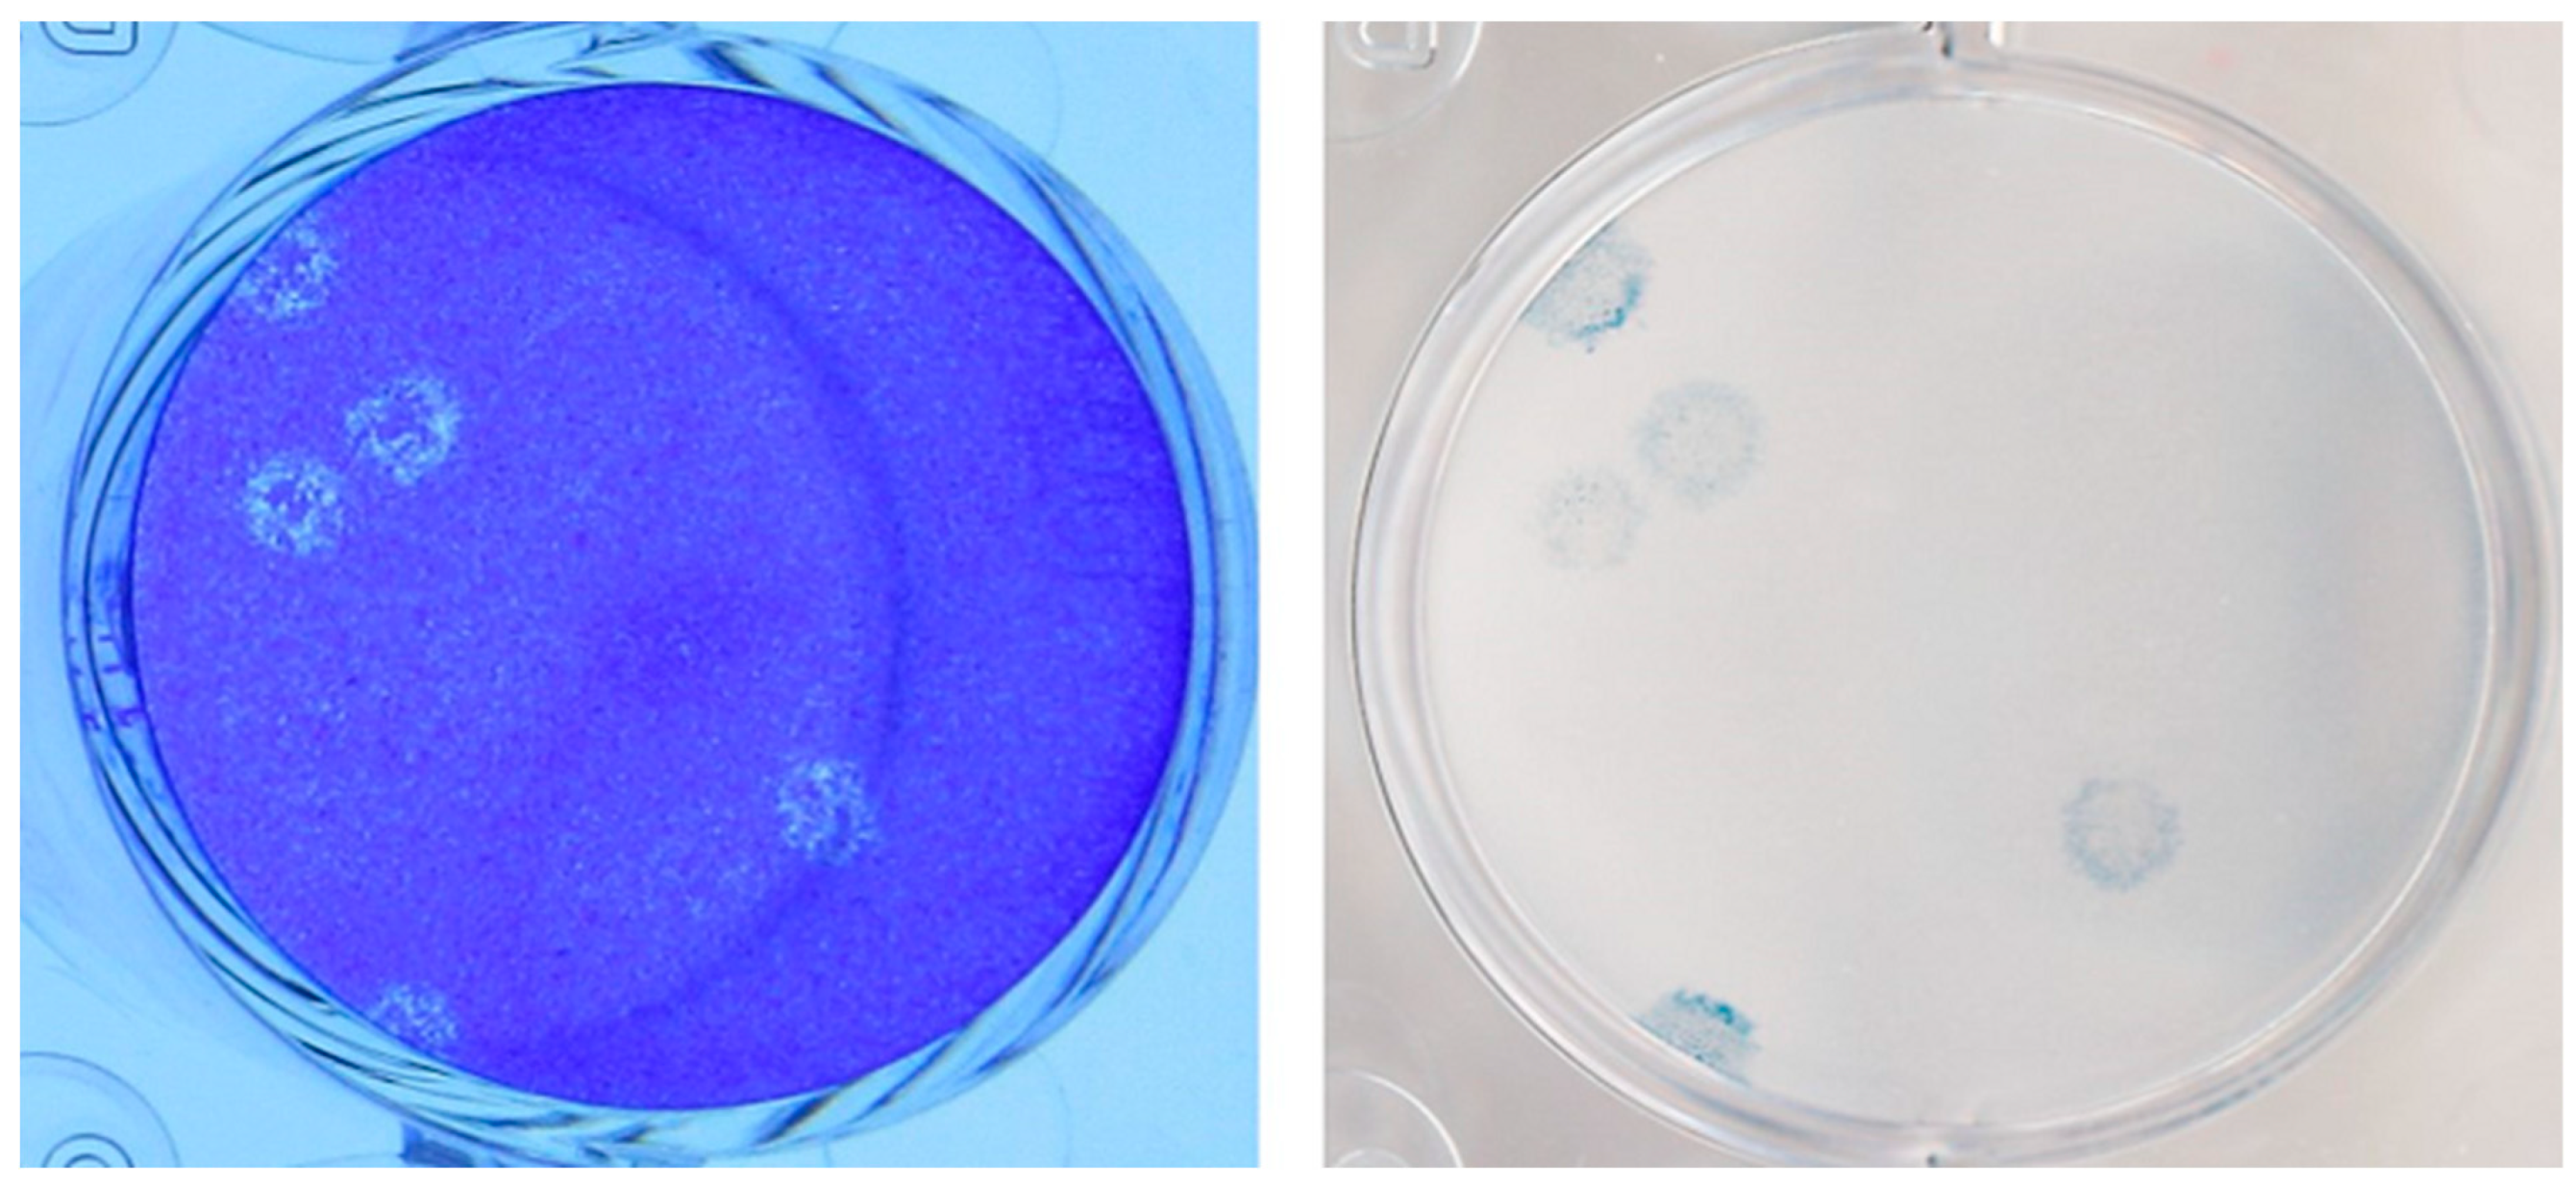
Viruses 15 01310 g001 Viruses 15 01310 g001

Congenital SARS-CoV-2 Infection in Two Neonates with Confirmation by Viral Culture of the Placenta in One Case
Abstract
1. Introduction
2. Materials and Methods
2.1. Viral Cultures
2.2. Consent and Ethics
3. Results
3.1. Case Presentation
3.1.1. Case 1 (December 2020)
3.1.2. Case 2 (January 2021)
3.2. Virology
3.3. Histopathology and Electron Microscopy
4. Discussion
4.1. Principal Findings
4.2. Clinical Implications
4.3. Research Implications
4.4. Strengths and Limitations
5. Conclusions
Supplementary Materials
Author Contributions
Funding
Institutional Review Board Statement
Informed Consent Statement
Data Availability Statement
Acknowledgments
Conflicts of Interest
References
- Wang, C.; Horby, P.W.; Hayden, F.G.; Gao, G.F. A novel coronavirus outbreak of global health concern. Lancet 2020, 395, 470–473. [Google Scholar] [CrossRef] [PubMed]
- Han, Y.; Yang, H. The transmission and diagnosis of 2019 novel coronavirus infection disease (COVID-19): A Chinese perspective. J. Med. Virol. 2020, 92, 639–644. [Google Scholar] [CrossRef]
- Chen, H.; Guo, J.; Wang, C.; Luo, F.; Yu, X.; Zhang, W.; Li, J.; Zhao, D.; Xu, D.; Gong, Q.; et al. Clinical characteristics and intrauterine vertical transmission potential of COVID-19 infection in nine pregnant women: A retrospective review of medical records. Lancet 2020, 395, 10809–10815. [Google Scholar] [CrossRef]
- Edlow, A.G.; Li, J.Z.; Collier, A.Y.; Atyeo, C.; James, K.E.; Boatin, A.A.; Gray, K.J.; Bordt, E.A.; Shook, L.L.; Yonker, L.M.; et al. Assessment of Maternal and Neonatal SARS-CoV-2 Viral Load, Transplacental Antibody Transfer, and Placental Pathology in Pregnancies During the COVID-19 Pandemic. JAMA Netw. Open 2020, 3, e2030455. [Google Scholar] [CrossRef]
- Papapanou, M.; Papaioannou, M.; Petta, A.; Routsi, E.; Farmaki, M.; Vlahos, N.; Siristatidis, C. Maternal and Neonatal Characteristics and Outcomes of COVID-19 in Pregnancy: An Overview of Systematic Reviews. Int. J. Environ. Res. Public Health 2021, 18, 596. [Google Scholar] [CrossRef]
- Yan, J.; Guo, J.; Fan, C.; Juan, J.; Yu, X.; Li, J.; Feng, L.; Li, C.; Chen, H.; Qiao, Y.; et al. Coronavirus disease 2019 in pregnant women: A report based on 116 cases. Am. J. Obs. Gynecol. 2020, 223, 111.e1–111.e14. [Google Scholar] [CrossRef] [PubMed]
- Qiancheng, X.; Jian, S.; Lingling, P.; Lei, H.; Xiaogan, J.; Weihua, L.; Gang, Y.; Shirong, L.; Zhen, W.; GuoPing, X.; et al. Coronavirus disease 2019 in pregnancy. Int. J. Infect. Dis. 2020, 95, 376–383. [Google Scholar] [CrossRef] [PubMed]
- Alzamora, M.C.; Paredes, T.; Caceres, D.; Webb, C.M.; Valdez, L.M.; La Rosa, M. Severe COVID-19 during Pregnancy and Possible Vertical Transmission. Am. J. Perinatol. 2020, 37, 861–865. [Google Scholar] [CrossRef]
- Chi, J.; Gong, W.; Gao, Q. Clinical characteristics and outcomes of pregnant women with COVID-19 and the risk of vertical transmission: A systematic review. Arch. Gynecol. Obs. 2021, 303, 337–345. [Google Scholar] [CrossRef]
- Kotlyar, A.M.; Grechukhina, O.; Chen, A.; Popkhadze, S.; Grimshaw, A.; Tal, O.; Taylor, H.S.; Tal, R. Vertical transmission of coronavirus disease 2019: A systematic review and meta-analysis. Am. J. Obs. Gynecol. 2021, 224, 35–53 e33. [Google Scholar] [CrossRef]
- Kirtsman, M.; Diambomba, Y.; Poutanen, S.M.; Malinowski, A.K.; Vlachodimitropoulou, E.; Parks, W.T.; Erdman, L.; Morris, S.K.; Shah, P.S. Probable congenital SARS-CoV-2 infection in a neonate born to a woman with active SARS-CoV-2 infection. CMAJ 2020, 192, E647–E650. [Google Scholar] [CrossRef] [PubMed]
- Garcia-Ruiz, I.; Sulleiro, E.; Serrano, B.; Fernandez-Buhigas, I.; Rodriguez-Gomez, L.; Sanchez-Nieves Fernandez, D.; Anton-Pagarolas, A.; Esperalba-Esquerra, J.; Frick, M.A.; Camba, F.; et al. Congenital infection of SARS-CoV-2 in live-born neonates: A population-based descriptive study. Clin. Microbiol. Infect. 2021, 27, 1521.e1–1521.e5. [Google Scholar] [CrossRef] [PubMed]
- Sisman, J.; Jaleel, M.A.; Moreno, W.; Rajaram, V.; Collins, R.R.J.; Savani, R.C.; Rakheja, D.; Evans, A.S. Intrauterine Transmission of SARS-CoV-2 Infection in a Preterm Infant. Pediatr. Infect. Dis. J. 2020, 39, e265–e267. [Google Scholar] [CrossRef] [PubMed]
- Facchetti, F.; Bugatti, M.; Drera, E.; Tripodo, C.; Sartori, E.; Cancila, V.; Papaccio, M.; Castellani, R.; Casola, S.; Boniotti, M.B.; et al. SARS-CoV2 vertical transmission with adverse effects on the newborn revealed through integrated immunohistochemical, electron microscopy and molecular analyses of Placenta. EBioMedicine 2020, 59, 102951. [Google Scholar] [CrossRef]
- Best Rocha, A.; Stroberg, E.; Barton, L.M.; Duval, E.J.; Mukhopadhyay, S.; Yarid, N.; Caza, T.; Wilson, J.D.; Kenan, D.J.; Kuperman, M.; et al. Detection of SARS-CoV-2 in formalin-fixed paraffin-embedded tissue sections using commercially available reagents. Lab. Investig. 2020, 100, 1485–1489. [Google Scholar] [CrossRef]
- Pabbaraju, K.; Wong, A.A.; Ma, R.; Zelyas, N.; Tipples, G.A. Development and validation of a multiplex reverse transcriptase-PCR assay for simultaneous testing of influenza A, influenza B and SARS-CoV-2. J. Virol. Methods 2021, 293, 114151. [Google Scholar] [CrossRef]
- Lin, Y.C.; Malott, R.J.; Ward, L.; Kiplagat, L.; Pabbaraju, K.; Gill, K.; Berenger, B.M.; Hu, J.; Fonseca, K.; Noyce, R.S.; et al. Detection and quantification of infectious severe acute respiratory coronavirus-2 in diverse clinical and environmental samples. Sci. Rep. 2022, 12, 5418. [Google Scholar] [CrossRef]
- Akilesh, S.; Nicosia, R.F.; Alpers, C.E.; Tretiakova, M.; Hsiang, T.Y.; Gale, M., Jr.; Smith, K.D. Characterizing Viral Infection by Electron Microscopy: Lessons from the Coronavirus Disease 2019 Pandemic. Am. J. Pathol. 2021, 191, 222–227. [Google Scholar] [CrossRef]
- Wurtz, N.; Penant, G.; Jardot, P.; Duclos, N.; La Scola, B. Culture of SARS-CoV-2 in a panel of laboratory cell lines, permissivity, and differences in growth profile. Eur. J. Clin. Microbiol. Infect. Dis. 2021, 40, 477–484. [Google Scholar] [CrossRef]
- ACOG Practice Bulletin No. 106: Intrapartum fetal heart rate monitoring: Nomenclature, interpretation, and general management principles. Obs. Gynecol. 2009, 114, 192–202. [CrossRef]
- Definition and Categorization of the Timing of Mother-to-Child Transmission of SARS-CoV-2. Available online: https://www.who.int/publications/i/item/WHO-2019-nCoV-mother-to-child-transmission-2021.1 (accessed on 14 April 2023).
- Schwartz, D.A.; Morotti, D.; Beigi, B.; Moshfegh, F.; Zafaranloo, N.; Patane, L. Confirming Vertical Fetal Infection With Coronavirus Disease 2019: Neonatal and Pathology Criteria for Early Onset and Transplacental Transmission of Severe Acute Respiratory Syndrome Coronavirus 2 From Infected Pregnant Mothers. Arch. Pathol. Lab. Med. 2020, 144, 1451–1456. [Google Scholar] [CrossRef] [PubMed]
- Bullock, H.A.; Goldsmith, C.S.; Miller, S.E. Detection and identification of coronaviruses in human tissues using electron microscopy. Microsc. Res. Tech. 2022, 85, 2740–2747. [Google Scholar] [CrossRef] [PubMed]
- Joshi, B.; Chandi, A.; Srinivasan, R.; Saini, S.S.; Prasad, G.R.V.; Puri, G.D.; Bhalla, A.; Suri, V.; Bagga, R. The placental pathology in Coronavirus disease 2019 infected mothers and its impact on pregnancy outcome. Placenta 2022, 127, 1–7. [Google Scholar] [CrossRef] [PubMed]
- Plüddemann, A.; Spencer, E.A.; Heneghan, C.J.; Brassey, J.; Onakpoya, I.J.; Rosca, E.C.; Evans, D.H.; Conly, J.M.; Jefferson, T. SARS-CoV-2 and the role of vertical transmission from infected pregnant women to their fetuses: Systematic review. medRxiv 2021. preprint. [Google Scholar] [CrossRef]
- Schwartz, D.A.; Baldewijns, M.; Benachi, A.; Bugatti, M.; Collins, R.R.J.; De Luca, D.; Facchetti, F.; Linn, R.L.; Marcelis, L.; Morotti, D.; et al. Chronic Histiocytic Intervillositis With Trophoblast Necrosis Is a Risk Factor Associated With Placental Infection From Coronavirus Disease 2019 (COVID-19) and Intrauterine Maternal-Fetal Severe Acute Respiratory Syndrome Coronavirus 2 (SARS-CoV-2) Transmission in Live-Born and Stillborn Infants. Arch. Pathol. Lab. Med. 2021, 145, 517–528. [Google Scholar] [CrossRef]
- Glynn, S.M.; Yang, Y.J.; Thomas, C.; Friedlander, R.L.; Cagino, K.A.; Matthews, K.C.; Riley, L.E.; Baergen, R.N.; Prabhu, M. SARS-CoV-2 and Placental Pathology: Malperfusion Patterns Are Dependent on Timing of Infection During Pregnancy. Am. J. Surg. Pathol. 2022, 46, 51–57. [Google Scholar] [CrossRef]
- Hecht, J.L.; Quade, B.; Deshpande, V.; Mino-Kenudson, M.; Ting, D.T.; Desai, N.; Dygulska, B.; Heyman, T.; Salafia, C.; Shen, D.; et al. SARS-CoV-2 can infect the placenta and is not associated with specific placental histopathology: A series of 19 placentas from COVID-19-positive mothers. Mod. Pathol. 2020, 33, 2092–2103. [Google Scholar] [CrossRef]
- Sharps, M.C.; Hayes, D.J.L.; Lee, S.; Zou, Z.; Brady, C.A.; Almoghrabi, Y.; Kerby, A.; Tamber, K.K.; Jones, C.J.; Adams Waldorf, K.M.; et al. A structured review of placental morphology and histopathological lesions associated with SARS-CoV-2 infection. Placenta 2020, 101, 13–29. [Google Scholar] [CrossRef]
- Qiu, L.; Liu, X.; Xiao, M.; Xie, J.; Cao, W.; Liu, Z.; Morse, A.; Xie, Y.; Li, T.; Zhu, L. SARS-CoV-2 Is Not Detectable in the Vaginal Fluid of Women With Severe COVID-19 Infection. Clin. Infect. Dis. 2020, 71, 813–817. [Google Scholar] [CrossRef]
- Aslan, M.M.; Uslu Yuvaci, H.; Kose, O.; Toptan, H.; Akdemir, N.; Koroglu, M.; Cevrioglu, A.S.; Ozden, S. SARS-CoV-2 is not present in the vaginal fluid of pregnant women with COVID-19. J. Matern.-Fetal Neonatal Med. 2020, 35, 2876–2878. [Google Scholar] [CrossRef]
- Picone, O.; Vivanti, A.J.; Sibiude, J.; Cordier, A.G.; Alessandrini, V.; Kayem, G.; Borie, C.; Luton, D.; Manchon, P.; Couffignal, C.; et al. SARS-CoV-2 excretion and maternal-fetal transmission: Virological data of French prospective multi-center cohort study COVIPREG during the first wave. J. Gynecol. Obs. Hum. Reprod. 2023, 52, 102547. [Google Scholar] [CrossRef] [PubMed]
- Schwartz, A.; Yogev, Y.; Zilberman, A.; Alpern, S.; Many, A.; Yousovich, R.; Gamzu, R. Detection of severe acute respiratory syndrome coronavirus 2 (SARS-CoV-2) in vaginal swabs of women with acute SARS-CoV-2 infection: A prospective study. BJOG 2021, 128, 97–100. [Google Scholar] [CrossRef]
- Roberts, D.J.; Edlow, A.G.; Romero, R.J.; Coyne, C.B.; Ting, D.T.; Hornick, J.L.; Zaki, S.R.; Das Adhikari, U.; Serghides, L.; Gaw, S.L.; et al. A standardized definition of placental infection by SARS-CoV-2, a consensus statement from the National Institutes of Health/Eunice Kennedy Shriver National Institute of Child Health and Human Development SARS-CoV-2 Placental Infection Workshop. Am. J. Obs. Gynecol. 2021, 225, 593.e1–593.e9. [Google Scholar] [CrossRef] [PubMed]
- Woodworth, K.R.; Olsen, E.O.; Neelam, V.; Lewis, E.L.; Galang, R.R.; Oduyebo, T.; Aveni, K.; Yazdy, M.M.; Harvey, E.; Longcore, N.D.; et al. Birth and Infant Outcomes Following Laboratory-Confirmed SARS-CoV-2 Infection in Pregnancy—SET-NET, 16 Jurisdictions, March 29-October 14, 2020. MMWR Morb. Mortal. Wkly. Rep. 2020, 69, 1635–1640. [Google Scholar] [CrossRef]
- Liguoro, I.; Pilotto, C.; Bonanni, M.; Ferrari, M.E.; Pusiol, A.; Nocerino, A.; Vidal, E.; Cogo, P. SARS-CoV-2 infection in children and newborns: A systematic review. Eur. J. Pediatr. 2020, 179, 1029–1046. [Google Scholar] [CrossRef] [PubMed]
- Dhir, S.K.; Kumar, J.; Meena, J.; Kumar, P. Clinical Features and Outcome of SARS-CoV-2 Infection in Neonates: A Systematic Review. J. Trop. Pediatr. 2021, 67, 1–14. [Google Scholar] [CrossRef] [PubMed]
- Sankaran, D.; Nakra, N.; Cheema, R.; Blumberg, D.; Lakshminrusimha, S. Perinatal SARS-CoV-2 Infection and Neonatal COVID-19: A 2021 Update. Neoreviews 2021, 22, e284–e295. [Google Scholar] [CrossRef]
- Zeng, L.; Xia, S.; Yuan, W.; Yan, K.; Xiao, F.; Shao, J.; Zhou, W. Neonatal Early-Onset Infection With SARS-CoV-2 in 33 Neonates Born to Mothers With COVID-19 in Wuhan, China. JAMA Pediatr. 2020, 174, 722–725. [Google Scholar] [CrossRef]
- Gale, C.; Quigley, M.A.; Placzek, A.; Knight, M.; Ladhani, S.; Draper, E.S.; Sharkey, D.; Doherty, C.; Mactier, H.; Kurinczuk, J.J. Characteristics and outcomes of neonatal SARS-CoV-2 infection in the UK: A prospective national cohort study using active surveillance. Lancet Child. Adolesc. Health 2021, 5, 113–121. [Google Scholar] [CrossRef]
- Dong, Y.; Mo, X.; Hu, Y.; Qi, X.; Jiang, F.; Jiang, Z.; Tong, S. Epidemiology of COVID-19 Among Children in China. Pediatrics 2020, 145, e20200702. [Google Scholar] [CrossRef]
- Knight, M.; Bunch, K.; Vousden, N.; Morris, E.; Simpson, N.; Gale, C.; O’Brien, P.; Quigley, M.; Brocklehurst, P.; Kurinczuk, J.J.; et al. Characteristics and outcomes of pregnant women admitted to hospital with confirmed SARS-CoV-2 infection in UK: National population based cohort study. BMJ 2020, 369, m2107. [Google Scholar] [CrossRef] [PubMed]
- Colson, A.; Depoix, C.L.; Dessilly, G.; Baldin, P.; Danhaive, O.; Hubinont, C.; Sonveaux, P.; Debieve, F. Clinical and in Vitro Evidence against Placenta Infection at Term by Severe Acute Respiratory Syndrome Coronavirus 2. Am. J. Pathol. 2021, 191, 1610–1623. [Google Scholar] [CrossRef] [PubMed]
- Kreis, N.N.; Ritter, A.; Louwen, F.; Yuan, J. A Message from the Human Placenta: Structural and Immunomodulatory Defense against SARS-CoV-2. Cells 2020, 9, 1777. [Google Scholar] [CrossRef] [PubMed]
- Jefferson, T.; Spencer, E.A.; Brassey, J.; Heneghan, C. Viral cultures for COVID-19 infectious potential assessment—A systematic review. Clin. Infect. Dis. 2020, 73, e3884-99. [Google Scholar] [CrossRef]

| Specimen Type | RT-PCR Cycle Threshold (Ct) Value | Assay Target(s) | Viral Culture Titer (pfu/mL) | Estimated Viral Load (N Gene Copies/mL) | Whole Genome Sequencing Lineage |
|---|---|---|---|---|---|
| NP Swab Mother | 21.0 | E gene | ND | N/A | B1.36.1 |
| NP Swab Neonate (24 h) | 22.8/23.0 | E gene | 4.0 × 102 | N/A | B1.36.1 |
| NP Swab Neonate (48 h) | 17.5 | E gene | N/A | N/A | Not performed |
| NP Swab Neonate (Day 14) | 34.2/36.7 | E gene | N/A | N/A | Not performed |
| NP Swab Neonate (Day 21) | 29.8/31.4 | E gene | N/A | N/A | Not performed |
| NP Swab Neonate (Day 31) | NEGATIVE | E gene | N/A | N/A | N/A |
| CSF (Day 7) | NEGATIVE | E gene | N/A | N/A | N/A |
| CordBlood ** (1:1 UTM) | 33.3 | N gene | ND | 7.0 × 102 | Not performed |
| Cord blood | 37.2 | E gene | ND | N/A | Not performed |
| Placenta | 24.9 | E gene | N/A | N/A | B1.36.1 |
| Placenta * | 16.0 | N gene | 2.8 × 102 | 8.9 × 107 | Not performed |
| Cord tissue * | 30.2 | N gene | ND | 5.9 × 103 | Not performed |
| Serology | Specimen | Target | Result | N/A | Manufacturers |
| Blood | Plasma (Day 6 of life) | COVID-19 Antibody IgG (nucleocapsid & spike) | NEGATIVE | Abbott Laboratories & DiaSorin |
| RT-PCR Specimen Type | RT-PCR Cycle Threshold (Ct) Value | Assay Target(s) | Assay |
|---|---|---|---|
| Mother NP swab | 23.5/25.4 | S gene/ORF1ab | Simplexa® |
| Placenta | 19.5 | E gene | ProvLab E gene |
| Cord Blood | 24.9 | E gene | ProvLab E gene |
| Neonate NP Swab–24 h | 26.4/29.1 | S gene/ORF1ab | Simplexa® |
| Neonate NP Swab–48 h | 14/15 | S gene/ORF1ab | Simplexa® |
| Neonate NP Swab–Day 18 | 26.5/27 | S gene/ORF1ab | Simplexa® |
| Serology | Result | Assay Target | Assay |
| Neonate Blood–Plasma | NEGATIVE (Day 1 of life) | COVID-19 Antibody IgG (Nucleocapsid & Spike) | Abbott Laboratories (Nucleocapsid) & DiaSorin (Spike) |
Disclaimer/Publisher’s Note: The statements, opinions and data contained in all publications are solely those of the individual author(s) and contributor(s) and not of MDPI and/or the editor(s). MDPI and/or the editor(s) disclaim responsibility for any injury to people or property resulting from any ideas, methods, instructions or products referred to in the content. |
© 2023 by the authors. Licensee MDPI, Basel, Switzerland. This article is an open access article distributed under the terms and conditions of the Creative Commons Attribution (CC BY) license (https://creativecommons.org/licenses/by/4.0/).
Share and Cite
Vayalumkal, J.V.; Soraisham, A.S.; Abou Mehrem, A.; Ghosh, A.; Dunn, J.K.E.; Fonseca, K.; Zhou, H.; Berenger, B.M.; Chan, E.S.; Brundler, M.-A.; et al. Congenital SARS-CoV-2 Infection in Two Neonates with Confirmation by Viral Culture of the Placenta in One Case. Viruses 2023, 15, 1310. https://doi.org/10.3390/v15061310
Vayalumkal JV, Soraisham AS, Abou Mehrem A, Ghosh A, Dunn JKE, Fonseca K, Zhou H, Berenger BM, Chan ES, Brundler M-A, et al. Congenital SARS-CoV-2 Infection in Two Neonates with Confirmation by Viral Culture of the Placenta in One Case. Viruses. 2023; 15(6):1310. https://doi.org/10.3390/v15061310
Chicago/Turabian StyleVayalumkal, Joseph V., Amuchou S. Soraisham, Ayman Abou Mehrem, Anirban Ghosh, Jessica K. E. Dunn, Kevin Fonseca, Hong Zhou, Byron M. Berenger, Elaine S. Chan, Marie-Anne Brundler, and et al. 2023. "Congenital SARS-CoV-2 Infection in Two Neonates with Confirmation by Viral Culture of the Placenta in One Case" Viruses 15, no. 6: 1310. https://doi.org/10.3390/v15061310
APA StyleVayalumkal, J. V., Soraisham, A. S., Abou Mehrem, A., Ghosh, A., Dunn, J. K. E., Fonseca, K., Zhou, H., Berenger, B. M., Chan, E. S., Brundler, M.-A., Lin, Y.-C., Evans, D. H., Rousso, S., Kuret, V., & Conly, J. M. (2023). Congenital SARS-CoV-2 Infection in Two Neonates with Confirmation by Viral Culture of the Placenta in One Case. Viruses, 15(6), 1310. https://doi.org/10.3390/v15061310






